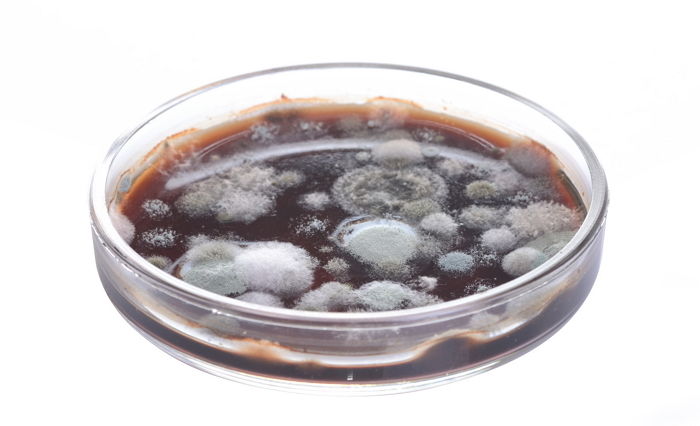
인사이트

기사와 관련 없는 자료 사진 / (좌) gettyimagesBank, (우) 뉴스1
기사와 관련 없는 자료 사진 / (좌) gettyimagesBank, (우) 뉴스1
[인사이트] 전현영 기자 = 플라스틱 컵 규제가 시작되면서 환경에 도움이 될 수 있는 '텀블러'에 대한 관심이 뜨겁다.
일부 카페에서는 텀블러 사용 시 할인 혜택을 제공하기도 해 환경 보호에 도움이 되는 동시에 절약 효과를 볼 수 있다.
텀블러를 이용하는 사람이 늘면서, 텀블러를 청결하게 이용하는 방법을 알려준 과거 방송 영상 한 편이 재조명되고 있다.
지난 2015년 1월 방송된 KBS2 '위기탈출 넘버원'에는 건강을 위협할 수 있는 텀블러 사용법이 공개됐다.
 KBS2 '위기탈출 넘버원'
KBS2 '위기탈출 넘버원'
이날 제작진은 아나운서실을 찾아 실제 이용 중인 텀블러의 오염도를 측정했다.
깔끔하다고 자부하던 그들의 텀블러에서는 젖은 행주와 비슷한 오염도, 변기보다 높은 오염도 수치가 나왔다.
매일 세척해 사용하는 텀블러에서 왜 이런 수치가 나오게 된 것일까.
이와 관련 미생물학과 교수는 "텀블러를 세척할 때 틈 사이사이나 각이 진 부분, 구조가 복잡한 뚜껑 쪽에 물기가 남아 있게 된다. 곰팡이들이 텀블러 속의 따뜻한 액체로 전파돼 빠르게 증식할 수 있다"고 설명했다.
 KBS2 '위기탈출 넘버원'
KBS2 '위기탈출 넘버원'
잘못된 세척 방법 때문에 텀블러의 오염도가 증가할 수 있다는 것이다.
이를 막기 위해서는 텀블러를 세척한 후 말릴 때 꼼꼼하게 확인할 점이 있다.
표면의 물기를 마른 수건으로 닦아준 후 통풍이 잘되는 곳에서 뚜껑을 열고 말려야 하고, 뒤집어 말릴 때도 철망 등에 올려 통풍이 잘되도록 해야 한다.
전문가는 물기를 제대로 제거하지 않고 사용할 경우, 여러 가지 감염의 원인이 될 수 있으니 주의해야 한다고 강조했다.
 KBS2 '위기탈출 넘버원'
KBS2 '위기탈출 넘버원'
기사와 관련 없는 자료 사진 / gettyimagesbank
기사와 관련 없는 자료 사진 / gettyimagesbank